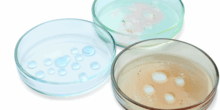

February 2026 2026 Research Forecast As we move into 2026, the Australian homeopathic research community in The Aurum Project continues to deepen its reach into the research projects that have been underway. This year we have several milestones you can look forward to learning more about. Conference Spotlight: 14th AHMC Brisbane We are thrilled to […]